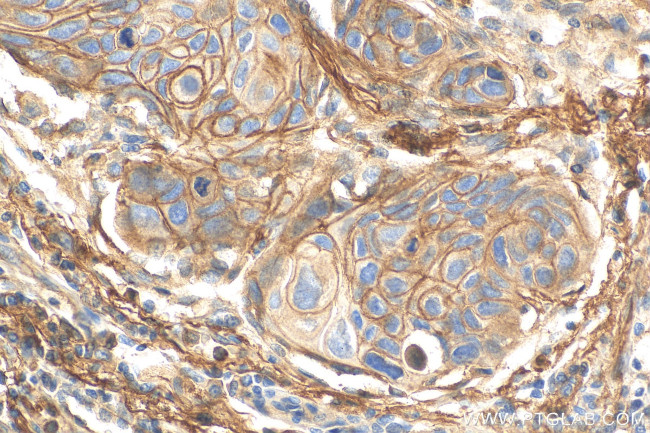
CD55 Antibody in Immunohistochemistry (Paraffin) (IHC (P))

Search
Proteintech
CD55 Recombinant Rabbit Monoclonal Antibody (2D2)
{{$productOrderCtrl.translations['antibody.pdp.commerceCard.promotion.promotions']}}
{{$productOrderCtrl.translations['antibody.pdp.commerceCard.promotion.viewpromo']}}
{{$productOrderCtrl.translations['antibody.pdp.commerceCard.promotion.promocode']}}: {{promo.promoCode}} {{promo.promoTitle}} {{promo.promoDescription}}. {{$productOrderCtrl.translations['antibody.pdp.commerceCard.promotion.learnmore']}}
产品信息
82781-6-RR
种属反应
宿主/亚型
Expression System
分类
类型
克隆号
抗原
偶联物
形式
浓度
纯化类型
保存液
内含物
保存条件
运输条件
产品详细信息
Immunogen sequence: DCGLPPDVPN AQPALEGRTS FPEDTVITYK CEESFVKIPG EKDSVICLKG SQWSDIEEFC NRSCEVPTRL NSASLKQPYI TQNYFPVGTV VE
靶标信息
CD55 (decay-accelerating factor, DAF) is a GPI-anchored membrane glycoprotein that protects autologous cells from classical and alternative pathway of complement cascade. Bidirectional interactions between CD55 and CD97 are involved in T cell regulation and CD55 can regulate complement when bound to CD97. In tumors, CD55 promotes neoangiogenesis, tumorigenesis, invasiveness and evasion of apoptosis. CD55 is a 70 kDa glycoprotein (in erythrocytes) anchored in the membrane by glycosylphosphatidylinositol tail. In other cells, the apparent molecular weight is somewhat larger for CD55 and has a substantial content of O-glycans. CD55 binds to activated C4b or C3b complement fragments on the cell surface, preventing the assembly and accelerating the decay of both classical and alternative pathways. CD55 carries the Cromer related blood group antigens. Two alternatively spliced transcripts encoding CD55 have been identified, and the predominant transcript encodes a membrane-bound protein expressed on cells exposed to plasma component proteins but an alternatively spliced transcript produces a soluble protein present at much lower levels. CD55 has been studied to have a role in prostate cancer growth and survival.
仅用于科研。不用于诊断过程。未经明确授权不得转售。
篇参考文献 (0)
生物信息学
蛋白别名: CD55; CD55 antigen; CD55 molecule, decay accelerating factor for complement (Cromer blood group); Complement decay-accelerating factor; RP11-357P18.1
基因别名: CD55; CR; CROM; DAF; TC
UniProt ID: (Human) P08174
Entrez Gene ID: (Human) 1604